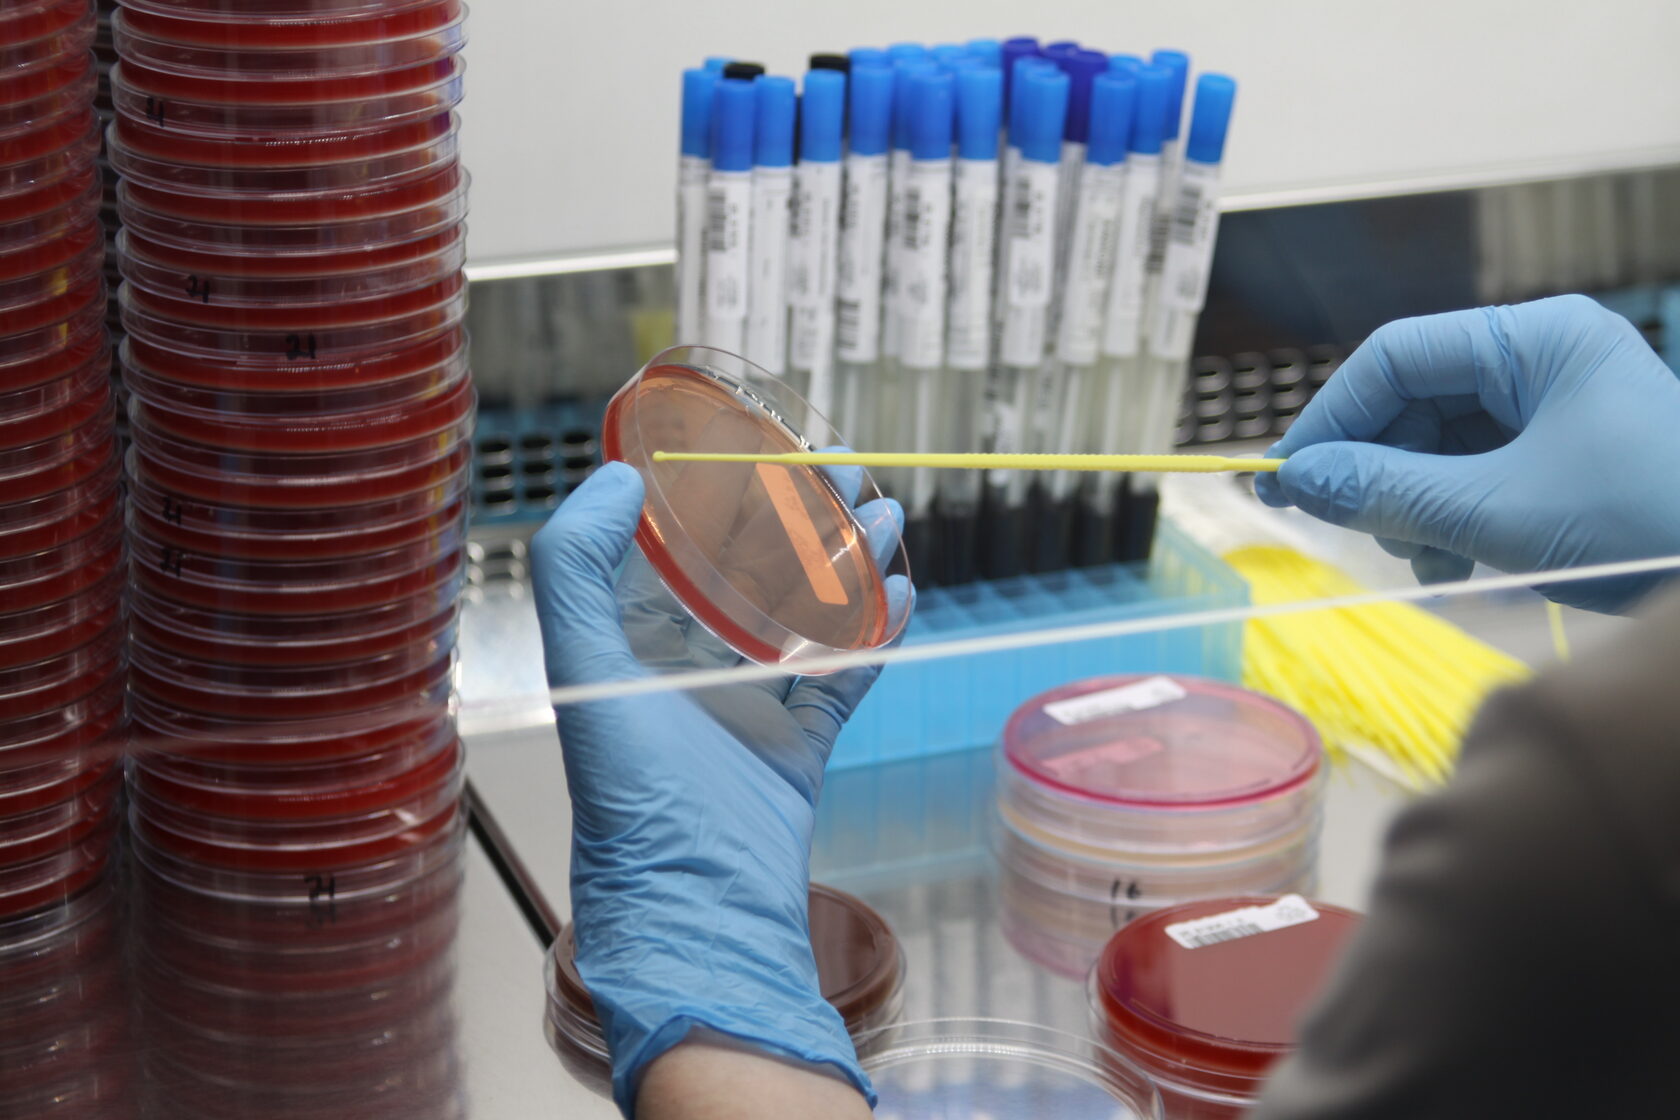

23 сентября представители Профкома посетили лабораторно-диагностический центр нового партнёра — «СМ-Клиника».
В ходе экскурсии активисты осмотрели три этажа современного комплекса, где познакомились с полным циклом исследований: от микробиологии и ПЦР-анализа до автоматизированной обработки биоматериалов.
Особый интерес вызвал разбор реального клинического случая, позволивший почувствовать себя настоящими медицинскими детективами.
Высокий профессионализм и радушие сотрудников клиники сделали визит не только информативным, но и по-настоящему тёплым!
Высокий профессионализм и радушие сотрудников клиники сделали визит не только информативным, но и по-настоящему тёплым!